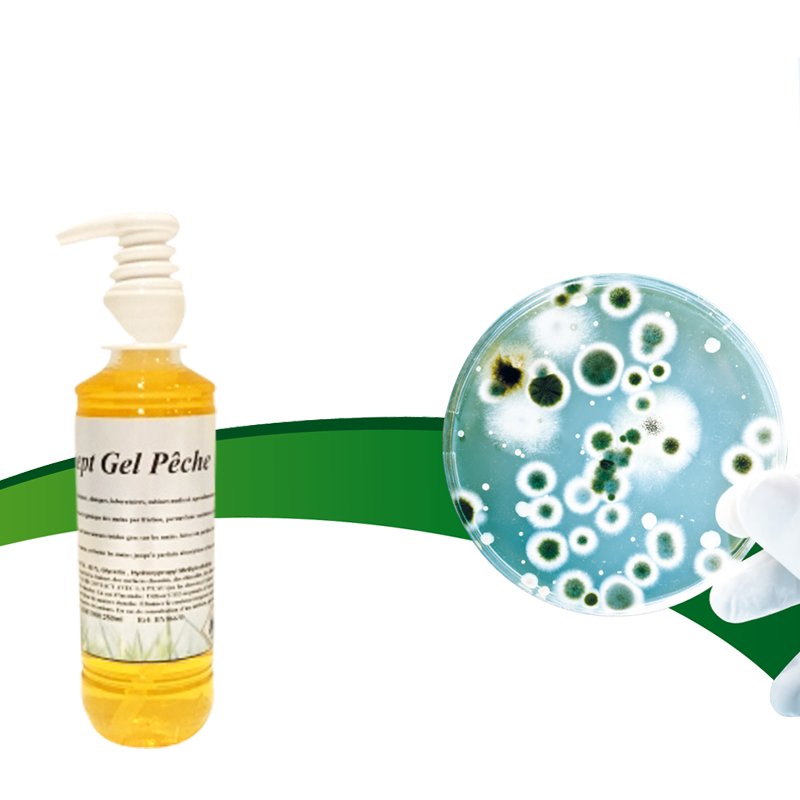

เจลล้างมือ250มล. สำหรับสุขอนามัยและการทำความสะอาด
ยังไม่มีรีวิว
คุณลักษณะ
สุขอนามัยร่างกายหมวดหมู่
250มล.ขนาด
น้ำหอม:สีพีช
คุณสมบัติที่สำคัญ
หมวดหมู่
สุขอนามัยร่างกาย
ขนาด
250มล.
น้ำหอม
สีพีช
บรรจุภัณฑ์และการนำส่ง
ขายหน่วย
รายการเดียว
คำอธิบายผลิตภัณฑ์จากซัพพลายเออร์
จำนวนสั่งซื้อขั้นต่ำ : 1 ชิ้น
฿459.60
จำนวน
การจัดส่ง
โซลูชันการจัดส่งสำหรับปริมาณที่เลือกไม่มีให้บริการในขณะนี้
ยอดรวมสินค้า
฿0.00
ค่าจัดส่งทั้งหมด
รอการต่อรอง
ยอดรวมย่อย
฿0.00
การคุ้มครองคำสั่งซื้อ Alibaba.com
การชำระเงินที่ปลอดภัย
ทุกการชำระเงินที่คุณทำบน Alibaba.com มีความปลอดภัยด้วยการเข้ารหัส SSL และโปรโตคอลการป้องกันข้อมูล PCI DSS ที่เข้มงวด
การคุ้มครองการคืนเงิน
รับเงินคืนหากคำสั่งซื้อไม่ถูกจัดส่ง สูญหาย หรือสินค้ามาถึงพร้อมกับปัญหาด้านคุณภาพ





